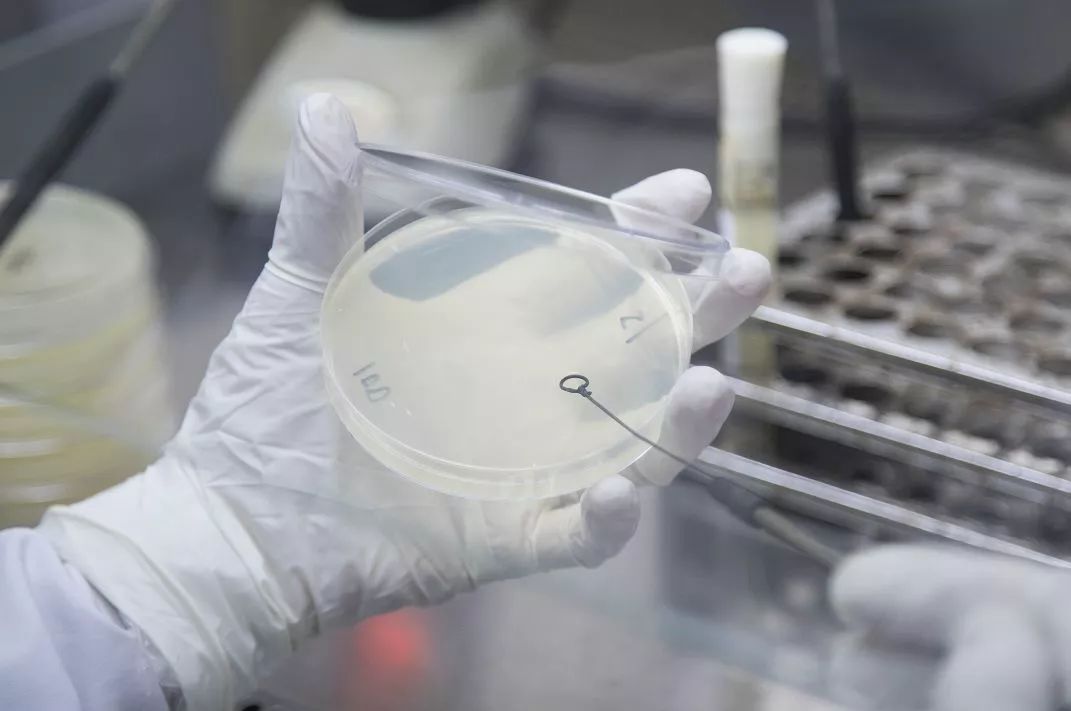
这样做你以为会干净却培养了十亿细菌

培养细菌

大肠杆菌细菌培养物白色背景
图片尺寸700x467
细菌培养所需组分索引
图片尺寸598x447
培养基是细菌分离鉴定的常用手段
图片尺寸640x385
天鹅绒发光, 紫病毒, f在选择性琼脂培养基ss琼脂上培养细菌菌落的
图片尺寸317x300
基因变异导致国际空间站出现"超级细菌"
图片尺寸623x480
细菌培养基图片
图片尺寸450x300
纯培养分离技术 细菌总数ppt
图片尺寸1080x810
冻干培养细菌的方法-范德生物科技公司
图片尺寸474x301
细菌培养细菌菌落酵母采用petroleum石油盘,微生物学为教育.
图片尺寸450x300
培养细菌细胞96孔 平底黑板 底透 透明盖 不灭菌包装
图片尺寸675x750
3,培养细菌,进行繁殖,观察微生物聚拢在一起的样子.
图片尺寸550x550
培养细菌
图片尺寸1280x1024
血培养肉汤内细菌直接涂片与转种平板后形态差异
图片尺寸2560x1920
科学家使用培养皿与各种细菌,组织和血液样本.
图片尺寸1200x675
一位研究人员手持细菌培养皿
图片尺寸404x272
看到这些培养皿,真心疼自己,长得还不如细菌
图片尺寸592x574
细菌在培养皿上的菌落.球菌, 杆菌
图片尺寸700x467
细菌总数显色培养基
图片尺寸700x1025
实验室显微镜和培养皿与细菌显微镜下细菌培养的分析显微镜下细菌的
图片尺寸700x467
这样做你以为会干净却培养了十亿细菌
图片尺寸1071x711